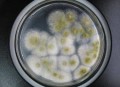
知名品牌菌落超48倍,菌落大全

大家好,今天小编关注到一个比较有意思的话题,就是关于舒淇曾备孕1年失败的问题,于是小编就整理了1个相关介绍舒淇曾备孕1年失败的解答,让我们一起看看吧。

为什么舒淇会发微博说暂告演员生涯?
12月5日,在余文乐结婚的消息大家还在懵懵懂懂的时候,又有一个消息让大家不知所措,那就是国民性感女神舒淇宣布自己暂时退出演戏生涯,至于什么时候回归,没有做出具体说明,我们又要暂时告别一位好演员了。

余文乐突然公布婚讯还没落下帷幕,女神舒淇深夜发微博说自己要暂告演员生涯,不仅如此还说承蒙错爱,引人遐想。4条评论都是舒淇后援会的休息休息的安慰之词,不过看着后援会的留言只是因为累了吗?更多不明真相的吃瓜群众在转发里已经排起了疑问的队形,更有媒体人萝贝贝问出了众多粉丝的心声——暂告,是暂时多久啊!
所以,暗搓搓地开个脑洞——不得不休息养养身体是不是因为女神要备孕或者已经怀孕了?不过不管怎么样,既然舒淇已经发博说要暂别演员生涯,那就表示舒淇只是暂时的累了想要休息休息,厚积薄发。不过只是希望这个暂时告别演员生涯之后会带给我们的是更好的消息啊!
此外舒淇接受台湾媒体电话求证时,回应了这件事情,舒淇称一觉醒来就被网传成这样表示很惊讶,其实是新戏刚杀青,需要休息、养病,希望大家不要想太多。而且医生警告不能一直拍戏,是暂休,不是退休。舒淇透露其实还是老毛病,脸部一直过敏,好长一段时间红肿好不了,这一次放长假要把这个过敏的毛病医好,才可以面对镜头。
原来是虚惊一场,舒淇只是单纯的杀青而已,正好蹭着休息把自己的脸部过敏治疗一下,其实舒淇一直都饱受过敏的困扰,也不止一次的在社交账号上面晒自己的过敏照片,奈何一直有工作,间隔时间太短,治疗过敏效果不佳,所以舒淇在微博中说“承蒙错爱”,估计是推掉了很多工作。看来这一次舒淇的下定决心一定要把脸部过敏医好了。
昨天的微博又热闹了,余文乐要和皮带大亨的千金结婚了,舒淇发微博要暂时告别演员生涯!
至于舒淇为什么暂别演员生涯,可能有以下几点原因:
首先,舒淇在娱乐圈打拼也有21年了,这么长的时间,在娱乐圈经历了太多的事情,她曾享受过众星捧月的荣光,也曾被人诟病。她现在年龄也不小了,与冯德伦结成夫妻后,可能想要过平淡的生活了!毕竟两个人不缺钱,就算现在舒淇在家专心做家庭主妇也能衣食无忧!或许是现在暂别娱乐圈调养身子,准备要孩子了!
其次,舒淇长期受皮肤病的困扰,皮肤病虽然不是什么疑难杂症,但是应该挺折磨人的!能长时间忍受这种痛苦也不是件容易的事!她又不缺钱,估计想放慢节奏,享受生活吧!
到此,以上就是小编对于舒淇曾备孕1年失败的问题就介绍到这了,希望介绍关于舒淇曾备孕1年失败的1点解答对大家有用。